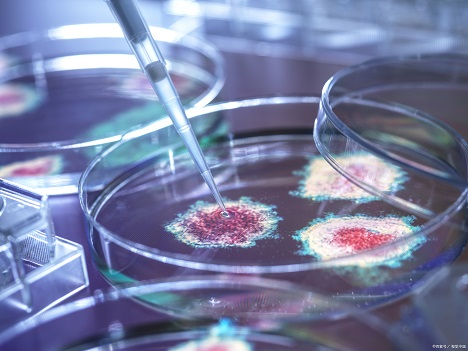

细胞培养实验常见的污染源及解决方法
细胞培养是指将细胞从动物或植物体内取出,然后在适宜的人工环境中生长的过程。细胞可以在培养前直接从组织中取出并通过酶或机械方法进行解离,也可以来源于已建立的细胞系或细胞株。细胞常规培养是在细胞房中进行,在超净工作台或生物安全柜中,把细胞处理好,根据需要加入细胞培养基,放入细胞培养瓶/皿或细胞培养板中,再放到带有5% CO2 的37℃恒温培养箱中培养。细胞培养过程中如果操作不当或者条件控制不合适容易受到化学或者生物因素的污染,常见的污染源及解决方法如下:
1、细菌:
细菌污染是实验室细胞培养中常见的污染,即使在细胞培养液中加入了抗菌素,也可能因为操作不慎而引起污染。常见的有革兰氏阳性菌,如枯草杆菌以及大肠杆菌、假单胞菌等革兰氏阴性菌,其中又以白色葡萄球菌较常见。
培养细胞受细菌污染后,会出现培养液变混浊,pH改变。污染后细胞发生病理改变,胞内颗粒增多、增粗,后变圆脱落死亡。 细菌在普通倒置显微镜下为黑色细沙状,根据感染细菌的不同,可有不同的外形,培养液一般会浑浊变黄,对细胞生长影响明显。
解决方法:
仔细检查一下器皿的灭菌情况,是否在高压灭菌时放气时间足够,压力足够!尤其是和储存培养液接触的移液管等物品,连续两次污染的话有可能造成储存液污染,一定要注意!下次使用前检查一下培养液是否存在浑浊的现象!可在培养液中加相应的抗生素处理,如四环素,庆大霉素,或者链霉素。
2、霉菌:
培养液是清亮的,倒置显微镜下无杂质,37度孵箱培养2-3天,仍清亮,但出现絮状杂质,镜下可见呈细丝状的团状漂浮物,可看到明显的菌丝,细胞仍可生长,但时间长之后,细胞的活力状态变差。
解决方法:
用硫酸铜溶液擦拭CO₂孵箱内,再把水盘里也加上饱和量的硫酸铜。或者在培养箱的托盘加入饱和的消毒磷酸氢二钠高盐液体,可以防止霉菌污染。
CO₂孵箱被霉菌污染后,可把所有细胞暂时转移,采用过氧乙酸擦洗孵箱(包括隔板,箱壁)。并把过氧乙酸放置在孵箱内一个小时,使其蒸汽弥漫。待过氧乙酸的气味消散后,再移入细胞。孵箱应定期清洁(2月左右),尤其在多雨的季节。
其它培养箱清洗方法是:用84液擦洗-清水擦洗-75%酒精擦洗-紫外灯照。
预防霉菌污染,可在培养基里加3u/ml的两性霉素或制霉菌素或放线菌素D或双抗;但细胞一旦污染,很难挽救,制霉菌素或放线菌素D或双抗都于事无补,建议舍弃该污染细胞。,将环境彻底消毒,如果所有细胞都污染,可能是系统污染,检查一下培养基和器材,如果只是个别污染,可能是操作问题,就要注意操作
3、支原体:
黑色的,好象多为多形,培养液一般培养液一般会浑浊,原体感染,国内血清很多都没有做支原体阴性检测,而支原体是牛血清中最常见的微生物之一。而且它不能用过滤的办法除去。支原体感染细胞以后,细胞病变不很明显,只是慢慢死去。
解决方法:
支原体污染细胞后,特别是重要的细胞株,有必要清除支原体,常用方法有:抗生素处理、抗血清处理、抗生素加抗血清和补体联合处理。要注意的是:支原体没有细胞壁,故作用于细胞壁生物合成的抗生素,如内酰胺类、万古霉素等是不敏感的;对多粘菌素、利福平、磺胺药物普遍耐火药。对支原体最有抑制活性抗生素是四环素类、大环内酯类等,氨基糖苷类、氯霉素对支原体有较小的抑制作用。必要时更换所有培养用物。通常,滤过除菌的方法对支原体是没有作用的。
4、黑蛟虫:
可以穿透滤膜,也可以通过空气传播,低倍下为黑色点状,高倍下可看见黑色的小虫游来游去,培养液也是不浑的,一般不会太影响,细胞还是可以用的。常常是细胞生长状态良好,且观测到的运动物无明显增多,且培养液颜色、透明度无明显变化,可在同一批号的血清养的细胞中发现类似现象。
解决方法:对细胞生长状态不会有明显影响,在细胞增殖旺盛之后会自然消失,除更换血清外无须特殊处理。建议如果细胞有可能是此种污染的话,可以增加细胞的种板密度,以提高细胞的生存率。
5、真菌:
一般培养液清亮,不变色,镜下有丝状物,有些真菌开始很像死细胞碎片,只是它很多很多的小块很清楚,象珊瑚状,不象细胞碎片分不清,慢慢的会长出很细的黑色丝状物。真菌生长的比较慢,不象细菌那么容易被发现,但是一旦发现有它的存在细胞就被污染了,也很难救活了。
解决方法:果断扔掉,然后彻底消毒灭菌培养间,CO₂孵箱,器皿和培养液。
6、原虫:
培养液可轻微浑浊,显微镜下那些细小的点状物数量非常多,轻微活动,细胞虽然可以生长但繁殖速度却明显减慢,而且细胞状态不好,边缘不清楚,细胞不透亮。它们与细胞可共生但会与细胞争夺营养。这种共生是非常普遍的,但它们的数量小,细胞占优势所以不会影响到细胞的正常生长,只有当它们到达一定的数量时就会影响到细胞的生长,最终形成恶性循环。
解决方法:污染的可能原因很多,比如配液消毒问题、操作问题、环境问题等等,如果细胞很多的话,直接扔了重新复苏细胞,如果是保种细胞的话,可购买相关的灭菌试剂。


